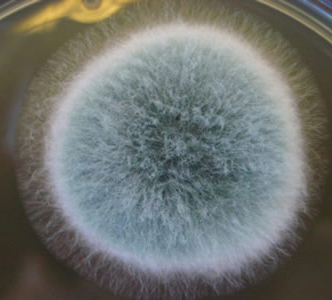

Types of Fungal (Mold) Spores
Alternaria sp.
Origin: Found on living plants, soil, decaying plant matter, textiles, indoor and outdoor air and other substrates. Some are saprophytic and other species are known to cause human and/or plant diseases. Common food rot fungus.
Health affects: Often the cause of sinusitis, hay fever and asthma. Can also cause keratomycosis, skin infections, osteomyelitis, pulmonary disease and nasal septum infections. Clinical impressions indicate the spores of Alternaria are the most potent aeroallergens.

Aspergillus sp.
Origin: This genus includes more than 600 species. Most of them are saprophytic, do not cause disease, and only a few are capable of being pathogenic to humans and plants. It is widespread in the environment, in soil, on plants, in the air, in foods and on decaying matter. This organism is common in indoor air. The enzyme of some Aspergillus species is used in the production of foods: for example, the production of industrial alcohols and soy sauce. Some are used in the breakdown of fatty or waxy substances, or in the production of antibiotics (A.niger). It is impossible to differentiate the species in air samples. It is not even recommended to attempt to differentiate Aspergillus from Penicillium.
Health effects: Aspergillosis (diseases caused by Aspergillus species) is usually acquired by inhalation of the spores. It begins as a pulmonary disease producing granulomatosis (tumorous) lesions in the lungs and bronchi. These can spread into surrounding blood vessels and to the rest of the body. It can also cause osteomycosis (external ear infections) and fungus ball (abscess). Asthma attacks can occur in sensitized individuals by inhalation of the spores. Other infections include: myocarditis, meningitis, osteomyelitis, mycetoma, burn infections, invasion of nasal sinuses, onychromycosis, keratomycosis and toxin ingestion by eating contaminated food.
Boletus sp.
Origin: This is a common mushroom and grows in wet conditions.
Health effects: Eating this mushroom has been known to cause anaphylaxis. Asthma and other allergic reactions can be attributed to individuals who have sensitivities to this spore and other basidiomycetes. Inhalation of the spores can also cause allergic reactions.

Botrytis sp.
Origin: Mostly a plant pathogen and food spoilage organism. Common in soil, air samples and on plants. Also found in indoor air. Could be ingested with contaminated food.
Health effects: Possible cause of allergies. The fact that it is found in food is also a method that it could cause allergic sensitivity. May be associated with corneal trauma and infections as it is found in the scrapings.

Cladosporium sp.
Origin: Found world wide. One of the most common fungal spores on air samples. Is often found in indoor air, damp walls, carpets, etc.. Certain species are food contaminants, others are found in woody rotting vegetation, soil, textiles, and cultivated and wild grasses.
Health effects: Some species are saprophytic and are not important in human or plant disease. Other species can cause systemic infections where initial inhalation leads to lung infections, which disseminates to other organs.The brain is sometimes involved. It is becoming more prevalent in patients with AIDS, organ transplants, leukaemia, autoimmune disease and Cushings Syndrome. Certain species can cause deep skin infections and can invade the central nervous system. They can contribute too sinusitis, respiratory diseases, and subcutaneous mycoses. May also cause keratomycosis and allergic reactions.
Lesions can occur anywhere in the body if a puncture occurs with contaminated vegetation.
The species in air samples are impossible to differentiate microscopically. This makes it impossible to separate the non-pathogenic species from the potentially pathogenic ones. Cladosporium, however, can occur in such high numbers, that it probably should always be considered as a possible source of infection when fungi are suspected.

Coprinus sp.
Origin: This is a common dark brown wild mushroom and grows in wet conditions. Found in abundance during damp wet summers.
Health effects: Due to the high numbers found and the size of the spore it should be treated as an important inhalant allergen.

Diatrypaceae sp.
Origin: Found in air samples, food, soil and plant material.
Health effects: Unknown

Epicoccum sp.
Origin: Found on plants, soil, grain, textiles, air samples and paper products. Causes damage to crops, corn, millet, soybean and cultivated grasses (wheat, oats, etc.)
Health effects: Can cause allergic reactions and can exacerbate asthma.

Erysiphe (Oospora) sp.
Origin: Erysiphe commonly known as Powdery Mildew is generally found on the foliage of cultivated and wild grasses.
Health effects: Not known to be allergenic.

Fusarium sp.
Origin: Found on decaying wood, agriculture crops, soil, humidifiers and the air. Some species are considered important food contaminants (cause food spoilage), and can produce potent toxins. Abundantly produced in humid conditions and released when the air is dry.
Health effects: Considered saprophytic. May be important source of health problems since large numbers do get airborne and they are a common food contaminant. Some species produce potent toxins and when infected food is ingested it can affect the following systems: circulatory, alimentary, skin and nervous. This can also be caused by inhalation of the sores. Symptoms can include nausea, vomiting, diarrhea, dermatitis and extensive internal bleeding. Can cause eye, sinusitis, skin and nail infections. Can cause hay fever and asthma. The most common cause of keratomycosis. It has also been isolated from skin lesions in burn patients, in onychomycosis (nail infection), otomycosis, varicose ulcers, mycetoma, osteomyelitis following trauma and disseminated infections.

Ganoderma sp.
Origin: Ganoderma aka Bracket Fungus occurs on tree stumps, rotten wood, fences and are often found in the gills of wild mushrooms. A common fungus on Hemlock trees. They are released in dry conditions and formed in favourable wet conditions. They are released in very high numbers in the late summer and throughout fall season.
Health effects: Due to high numbers it is probably a cause of allergic diseases. Basidiomycetes have been statistically connected to high hospital admissions for asthma when the counts are high.

Helicomyces sp.
Origin: Found on decaying wood.
Health effects: Considered to be saprophytic. Health effects unknown.

Leptosphaeria sp.
Origin: Found in air samples, food, soil and plant material.
Health effects: Can cause allergic diseases and asthma attacks. Cause of rhinitis and skin infections.

Penicillium sp.
Origin: Widespread in the environment. It is very common as a food spoilage organism and also in indoor environments. Common in soil, on plants and outdoor air. Some species of Penicillium are used for the production of special cheeses, certain acids and antibiotics. Common in foods such as corn, cereals, cheese, meat, nuts, fruits, rice etc.
Health effects: Infections are usually caused by inhalation of the spores. It starts as a pulmonary disease but may spread into the adjacent blood vessels. It disseminates to the rest of the body. Total invasion occurs in debilitated patients and can occur in immunocompetent (those with healthy immune systems) individuals as well. Penicillium species causes keratitis (inflammation of the cornea), keratomycosis, penicilliosis, ostomycosis, onychomycosis (infection of the nail) and deep infections. It has been know to cause external ear, respiratory, and urinary tract infections, and endocarditis after insertion of valve prostheses.

Pithomyces sp.
Origin: Grows on dead grasses in fields and rotting vegetation. Also found in paper and on tree bark and air samples.
Health effects: Etiologic agent in immune-compromised patients. Can cause disease in animals. Allergenicity not well established.

Torula sp.
Origin: Found in soil, dead vegetation, wood, grasses, nuts and oats and air samples. Also found indoors on cellulose.
Health effects: Reported to be allergenic. Can cause hay fever and asthma.

Ustilaginales sp.
Origin: Ustilaginales also know as Smuts are parasitic to seed and flowers of cereals and grasses.
Health effects: Due to high numbers found in air samples it should be treated as an important inhalant allergen. Can cause allergic reactions and can exacerbate asthma.

Uredinales sp.
Origin: Also know as Rusts, Uredinales is a plant parasite that grows on cultivated and wild grasses, flowers and trees. They also travel long distances from the South Central States up the Mississippi corridor to the Prairie Provinces of Canada. The Province of Manitoba sees particularly high numbers of these spores in the late summer and fall. It is of great importance to agriculture. It is also a problem indoors in humid basements.
Health effects: When in high numbers they may be of importance in causing disease. Can cause hay fever and asthma.

